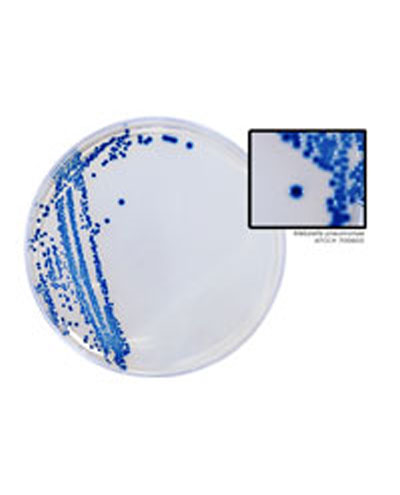
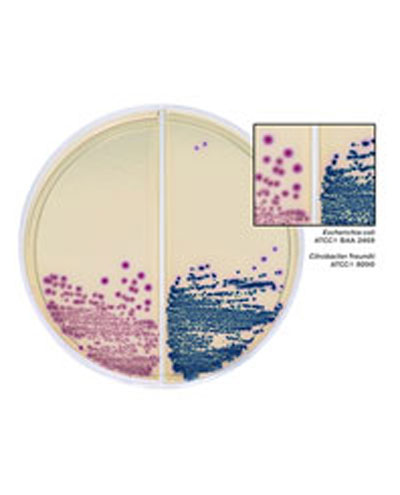

Experience Full Spectrum Innovation from Hardy Diagnostics
HardyCHROM™ is Hardy Diagnostics’ line of chromogenic, selective and differential culture media, recommended for use in cultivation, isolation, and identification of microorganisms. Hardy Diagnostics was the first company to introduce chromogenic media to the United States in 1996. Since then, Hardy Diagnostics has continued to innovate new and exciting chromogenic media formulations for clinical and industrial use.

HardyCHROM™ Candida
Selective medium for the isolation and identification of yeasts.

HardyCHROM™ CRE Agar
Selective and differential medium for the qualitative and presumptive detection of Escherichia coli that are non-susceptible to carbapenems.
HardyCHROM™ ESBL (Extended-Spectrum Beta-Lactamase) Agar
Selective and differential chromogenic medium for the detection of ESBL.
Selective and differential culture medium that facilitates the isolation and identification of MRSA.

HardyCHROM™ SS NoPRO Agar, (for Salmonella and Shigella)
Selective isolation and differentiation media for Salmonella and Shigella spp. that inhibits Proteus.
HardyCHROM™ Urine Biplate (HUrBi™)
Selective chromogenic medium recommended for the cultivation, differentiation, and enumeration of various gram-negative and gram-positive bacteria and yeast from urine.

HardyCHROM™ UTI, Chromogenic Medium for Urinary Pathogens
Differential culture medium that facilitates the isolation and differentiation of urinary tract pathogens.